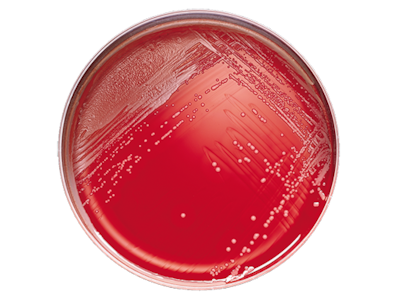
BD BBL Phenylethyl Alcohol Agar with 5% Sheep Blood Plate – 20 Plates, 84-Day Shelf Life, Prepared Culture

Description
BD BBL Phenylethyl Alcohol Agar with 5% Sheep Blood Plate supports reliable microorganism isolation for laboratories that need consistent, ready-to-use culture media. Designed for clinical and research professionals, this prepared agar plate streamlines sample processing and helps maintain workflow efficiency. Ideal for labs requiring fast setup and accurate results, each plate is ready for immediate use.
- Ready-to-Use Format – Eliminates preparation time, so you can focus on sample analysis with confidence.
- Consistent Quality – Manufactured to support diagnostic accuracy and efficiency, giving peace of mind in daily lab routines.
- 20 Plates per Pack – Provides ample supply for routine testing, reducing the need for frequent reordering.
- 84-Day Shelf Life – Ensures product viability for extended periods, supporting uninterrupted laboratory operations.
Prepared Culture Media for Reliable Microorganism Isolation
This prepared culture media is designed to enable the isolation of microorganisms from various samples or specimens. The BD BBL agar plate arrives ready for immediate use, saving valuable time in busy laboratory settings. Its phenylethyl alcohol formulation with 5% sheep blood supports selective growth and helps ensure accurate results. Laboratories benefit from the convenience and reliability of a product that is manufactured for diagnostic efficiency. With a pack of 20 plates and an 84-day shelf life, this solution fits the needs of clinical and research environments seeking consistent performance. Using this media helps streamline workflows and supports confidence in daily sample processing.
Features and Benefits
Diagnostic Efficiency
- Selective Growth Medium – Phenylethyl alcohol with 5% sheep blood supports targeted microorganism isolation for more precise results.
- Immediate Usability – Plates are supplied ready-to-use, minimizing setup time and supporting efficient lab operations.
Quality and Consistency
- Manufactured Standards – Produced to meet laboratory needs for consistent results in clinical and research applications.
- Batch Uniformity – Each pack contains plates with uniform quality, supporting reproducible outcomes.
Convenience and Supply
- 20-Pack Packaging – Sufficient quantity for routine use, helping labs maintain supply without frequent orders.
- Extended Shelf Life – 84-day shelf life supports long-term storage and readiness.
Product Specifications
General Information
- Category: Prepared culture media
- Pack Size: 20 plates
- Shelf Life: 84 days
Identification Codes
- SKU: 221179
- GTIN (Each): 00382902211792
- GTIN (Shelfpack): 30382902211793
- GTIN (Bag): 10382902211799
- GTIN (US Standard Pallet): 60382902211794
Explore More: See all Prepared Culture Media | Shop more BD BBL Products
Consistent Results and Laboratory Confidence
Choose this prepared agar plate for a dependable solution that supports accurate microorganism isolation. Compared to unprepared media, this product reduces setup time and helps maintain a steady workflow. The 20-pack format and extended shelf life offer practical advantages for labs managing routine testing. Rely on a product designed for efficiency and consistency in demanding laboratory environments.
- Time-Saving Solution – Ready-to-use plates help labs operate smoothly and avoid delays.
- Reliable Performance – Consistent manufacturing supports confidence in every test.
- Ample Supply – 20 plates per pack minimize interruptions in daily operations.
- Extended Viability – 84-day shelf life supports long-term planning and reduces waste.
Frequently Asked Questions (FAQs)
What is the main use of this prepared agar plate?
This product is used for isolating microorganisms from clinical or research samples in laboratory settings.
How many plates are included in each pack?
Each pack contains 20 plates, suitable for routine laboratory testing.
What is the shelf life of the plates?
The shelf life is 84 days, supporting extended storage and use.
Is the product ready to use upon arrival?
Yes, the plates are supplied ready for immediate use, eliminating the need for preparation.
What type of media is used in these plates?
The plates contain phenylethyl alcohol agar with 5% sheep blood for selective microorganism growth.
Who are the typical users of this product?
Clinical and research laboratories that require reliable culture media for microorganism isolation use this product.
Are there any storage requirements for these plates?
Store the plates as directed by laboratory protocols to maintain product viability throughout the shelf life.